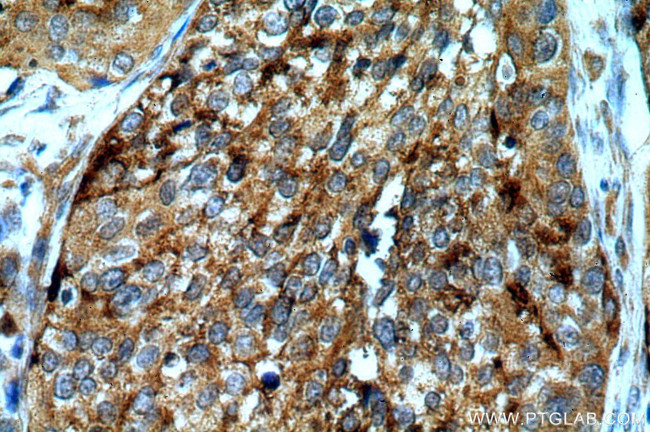
ARSA Antibody in Immunohistochemistry (Paraffin) (IHC (P))
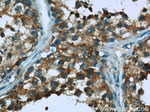
ARSA Antibody in Immunohistochemistry (Paraffin) (IHC (P))
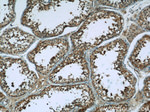
ARSA Antibody in Immunohistochemistry (Paraffin) (IHC (P))

Search
Proteintech
ARSA Polyclonal Antibody
{{$productOrderCtrl.translations['antibody.pdp.commerceCard.promotion.promotions']}}
{{$productOrderCtrl.translations['antibody.pdp.commerceCard.promotion.viewpromo']}}
{{$productOrderCtrl.translations['antibody.pdp.commerceCard.promotion.promocode']}}: {{promo.promoCode}} {{promo.promoTitle}} {{promo.promoDescription}}. {{$productOrderCtrl.translations['antibody.pdp.commerceCard.promotion.learnmore']}}
产品信息
19061-1-AP
种属反应
宿主/亚型
分类
类型
抗原
偶联物
形式
浓度
规格
纯化类型
保存液
内含物
保存条件
运输条件
产品详细信息
Immunogen sequence: PPNIVLIFA DDLGYGDLGC YGHPSSTTPN LDQLAAGGLR FTDFYVPVSL CTPSRAALLT GRLPVRMGMY PGVLVPSSRG GLPLEEVTVA EVLAARGYLT GMAGKWHLGV GPEGAFLPPH QGFHRFLGIP YSHDQGPCQN LTCFPPATPC DGGCDQGLVP IPLLANLSVE AQPPWLPGLE ARYMAFAHDL MADAQRQDRP FFLYYASHHT HYPQFSGQSF AERSGRGPFG DSLMELDAAV GTLMTAIGDL GLLEETLVIF TADNGPETMR MSRGGCSGLL RCG (20-301 aa encoded by BC014210)
靶标信息
The protein encoded by this gene hydrolyzes cerebroside sulfate to cerebroside and sulfate. Defects in this gene lead to metachromatic leucodystrophy, a progressive demyelination disease which results in a variety of neurological symptoms and ultimately death. Alternatively spliced transcript variants have been described for this gene.
仅用于科研。不用于诊断过程。未经明确授权不得转售。
篇参考文献 (0)
生物信息学
蛋白别名: ARSA; ARSA-I; ARSA1; Arylsulfatase A; ASA; ASNA-I; ATPase ASNA1; Cerebroside-sulfatase; EC 3.1.6.8; epididymis secretory sperm binding protein; GET3; hASNA-I; TRC40; unnamed protein product
基因别名: ARSA; As-2; AS-A; As2; ASA; AW212749; MLD; TISP73
UniProt ID: (Human) P15289, (Mouse) P50428
Entrez Gene ID: (Human) 410, (Rat) 315222, (Mouse) 11883